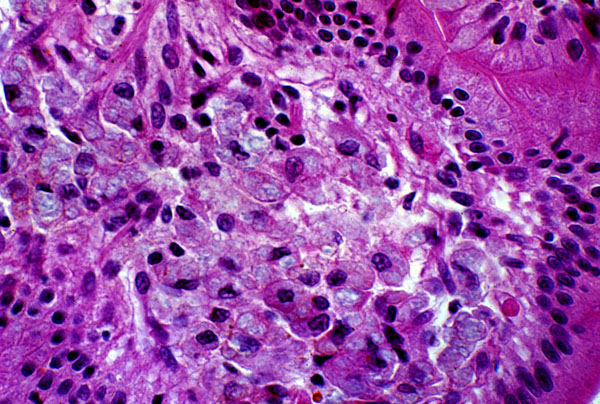

Whipple disease, histology
Click picture to enlarge. Close window to return
The central portion of the villi is infiltrated with histiocytes that have a granular cytoplasm. The cytoplasm of these histiocytes contains numerous bacteria, which are not seen by light microscopy.